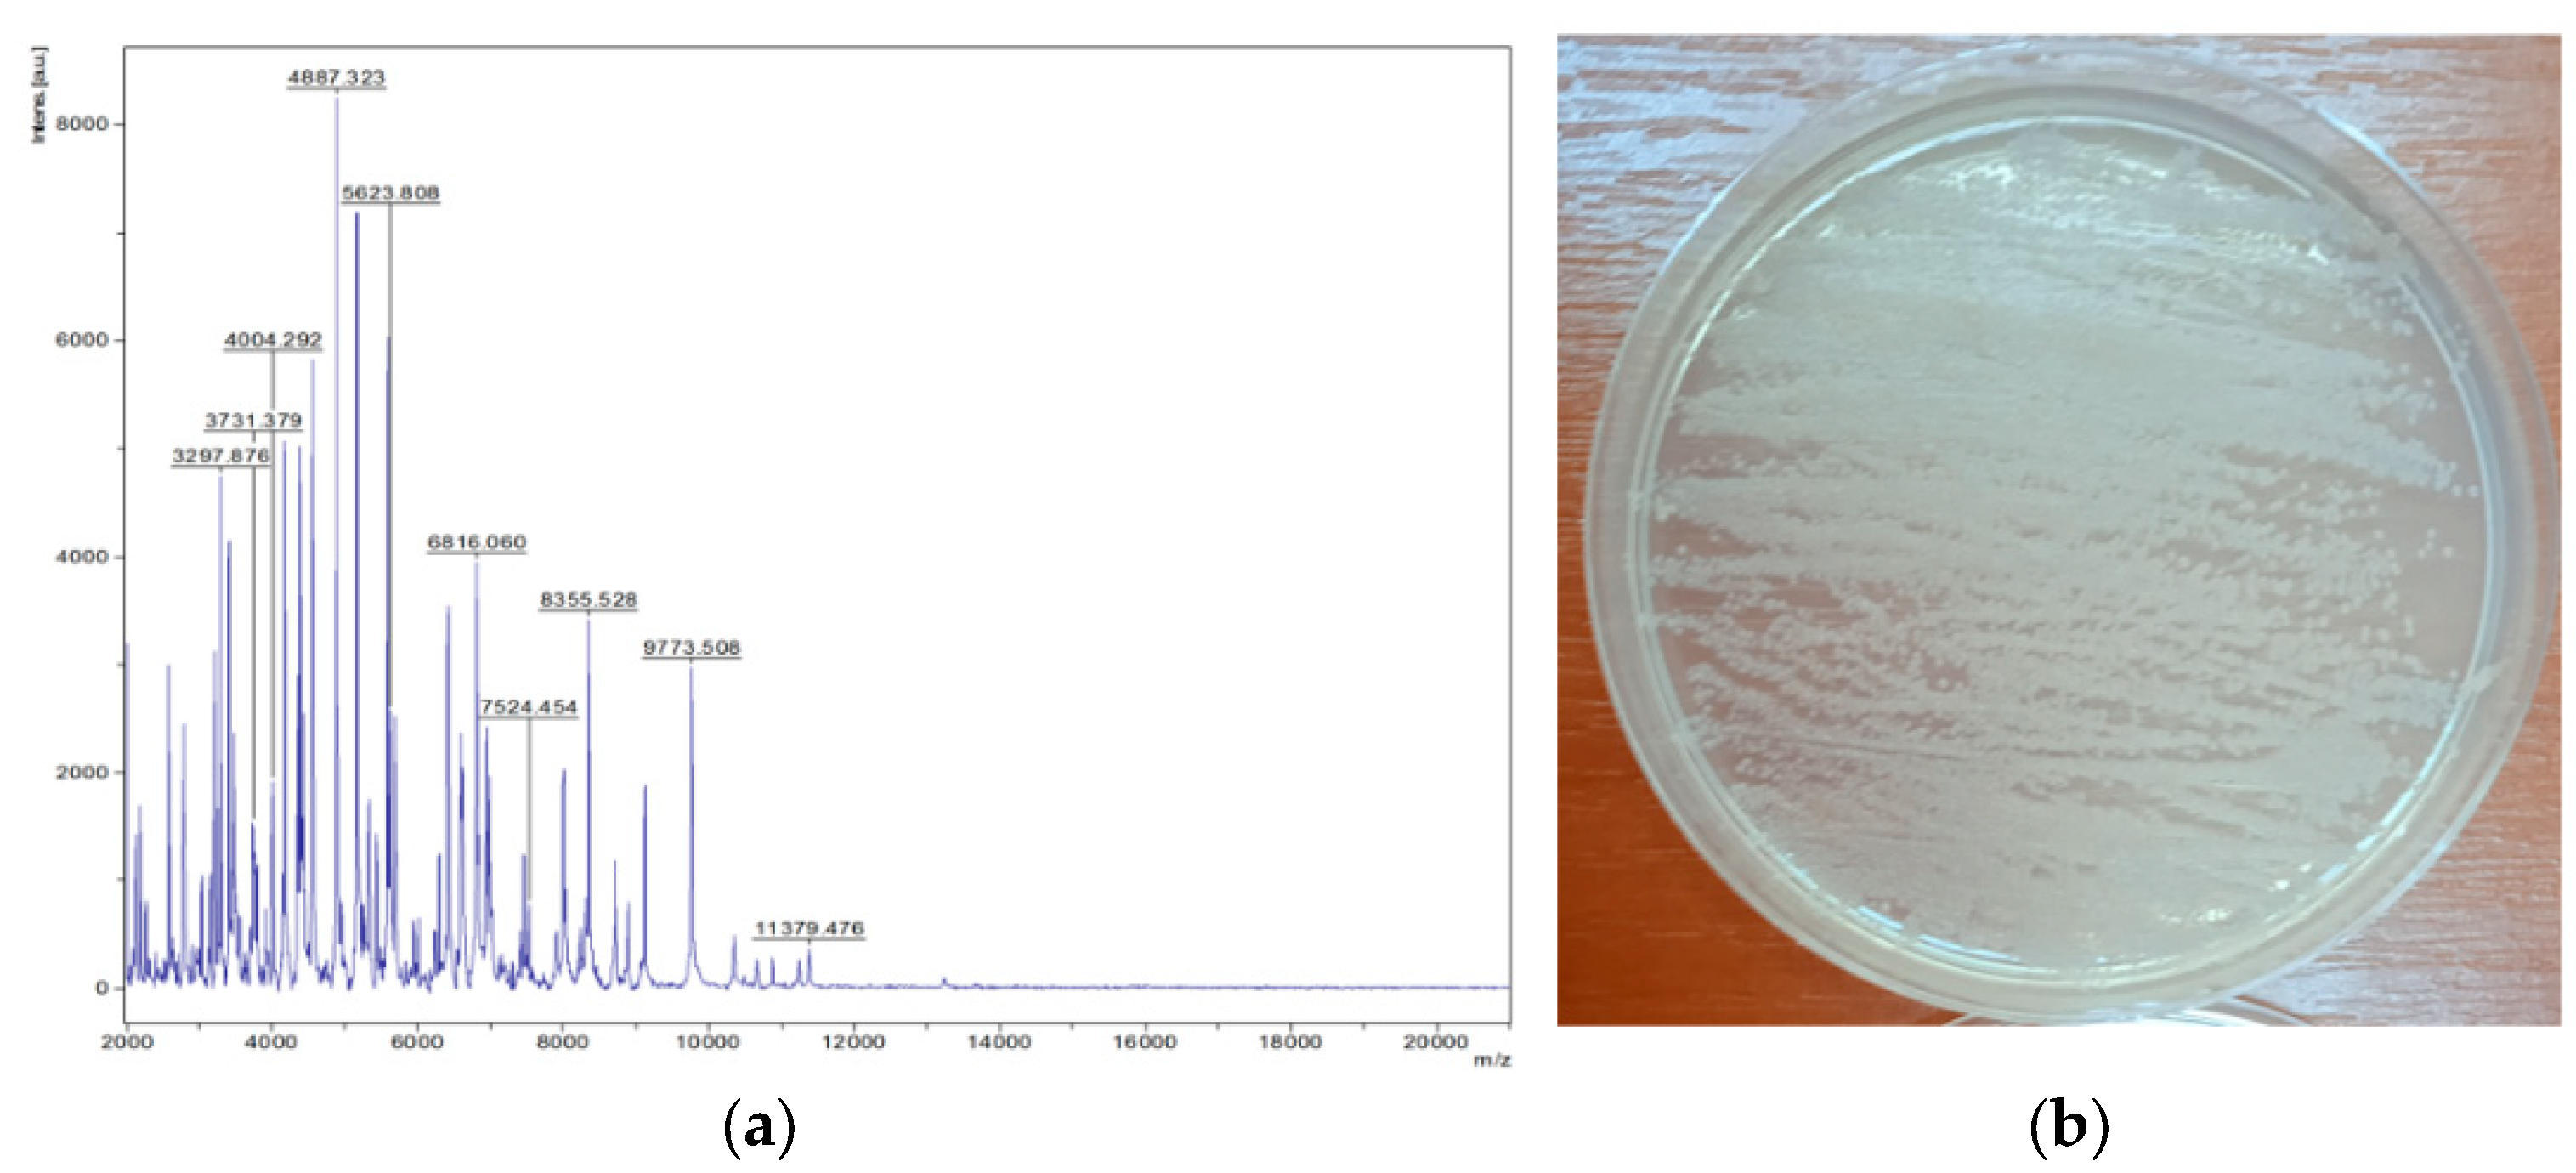
Applsci 15 00644 g010

Effect of Precision Nitrogen Fertilization of Grassland on Soil Microbial Structure
Abstract
1. Introduction
2. Materials and Methods
2.1. Experiment Detail
2.2. Identification of Sampling Locations
2.3. Microbiological Analysis
2.3.1. Collection and Preparation of Samples for Microbiological Analysis
2.3.2. Preparation of Culture Media for Isolation of Microorganisms
2.3.3. Microorganism Isolation
2.3.4. Species Identification of Microorganisms by MALD-TOF MS Technique
2.4. Determination of Nitrate Content by Colorimetric Method
2.5. Creating Digital Maps of Spatial Variation of Measured Quantities
- Zj—the value of the feature Z estimated at the point j,
- Zi—the value of feature Z measured at point i (one of the n data points in the environment),
- hij—effective distance between points i and j,
- β—power exponent–weight of distance.
2.6. Statistics
3. Results and Discussion
3.1. Determination of Nitrate Content
3.2. Quantitative and Qualitative Characteristics of Actinomycetes in the Soil Profile
3.3. Spatial Correlation Coefficients Between Isolated Actinomycetes Species and Soil Nitrate Content
4. Conclusions
Author Contributions
Funding
Institutional Review Board Statement
Informed Consent Statement
Data Availability Statement
Conflicts of Interest
References
- Bai, Z.; Caspari, T.; Gonzalez, M.R.; Batjes, N.H.; Mäder, P.; Bünemann, E.K.; Tóth, Z. Effects of agricultural management practices on soil quality: A review of long-term experiments for Europe and China. Agric. Ecosyst. Environ. 2018, 265, 1–7. [Google Scholar] [CrossRef]
- Dalgaard, T.; Hutchings, N.J.; Porter, J.R. Agroecology, scaling and interdisciplinarity. Agric. Ecosyst. Environ. 2003, 100, 39–51. [Google Scholar] [CrossRef]
- Techen, A.-K.; Helming, K.; Brüggemann, N.; Veldkamp, E.; Reinhold-Hurek, B.; Lorenz, M.; Bartke, S.; Heinrich, U.; Amelung, W.; Augustin, K.; et al. Soil research challenges in response to emerging agricultural soil management practices. Adv. Agron. 2020, 161, 179–240. [Google Scholar] [CrossRef]
- Ray, D.K.; Ramankutty, N.; Mueller, N.D.; West, P.C.; Foley, J.A. Recent Patterns of Crop Yield Growth and Stagnation. Nat. Commun. 2012, 3, 1293. [Google Scholar] [CrossRef]
- Lu, Y.; Liu, M.; Li, C.; Liu, X.; Cao, C.; Li, X.; Kan, Z. Precision Fertilization and Irrigation: Progress and Applications. Agriengineering 2022, 4, 626–655. [Google Scholar] [CrossRef]
- Silva, F.M.; Queirós, C.; Pereira, M.; Pinho, T.; Barroso, T.; Magalhães, S.; Boaventura, J.; Santos, F.; Cunha, M.; Martins, R.C. Precision Fertilization: A critical review analysis on sensing technologies for nitrogen, phosphorous and potassium quantification. Comput. Electron. Agric. 2024, 224, 109–220. [Google Scholar] [CrossRef]
- Radočaj, D.; Jurišić, M.; Gašparović, M.; Plaščak, I.; Antonić, O. Cropland Suitability Assessment Using Satellite-Based Biophysical Vegetation Properties and Machine Learning. Agronomy 2021, 11, 1620. [Google Scholar] [CrossRef]
- Pogrzeba, M.; Rusinowski, S.; Krzyżak, J. Macroelements and Heavy Metals Content in Energy Crops Cultivated on Contaminated Soil under Different Fertilization—Case Studies on Autumn Harvest. Environ. Sci. Pollut. Res. 2018, 25, 12096–12106. [Google Scholar] [CrossRef]
- Vizzari, M.; Santaga, F.; Benincasa, P. Sentinel 2-Based Nitrogen VRT Fertilization in Wheat: Comparison between Traditional and Simple Precision Practices. Agronomy 2019, 9, 278. [Google Scholar] [CrossRef]
- Bogunovic, I.; Pereira, P.; Brevik, E.C. Spatial Distribution of Soil Chemical Properties in an Organic Farm in Croatia. Sci. Total Environ. 2017, 584–585, 535–545. [Google Scholar] [CrossRef]
- Zha, H.; Miao, Y.; Wang, T.; Li, Y.; Zhang, J.; Sun, W.; Feng, Z.; Kusnierek, K. Improving Unmanned Aerial Vehicle Remote Sensing-Based Rice Nitrogen Nutrition Index Prediction with Machine Learning. Remote Sens. 2020, 12, 215. [Google Scholar] [CrossRef]
- Jurišić, M.; Radočaj, D.; Plaščak, I.; Rapčan, I. A Comparison of Precise Fertilization Prescription Rates to a Conventional Approach Based on the Open Source Gis Software. Poljoprivreda 2021, 27, 52–59. [Google Scholar] [CrossRef]
- Nogueira Martins, R.; Magalhaes Valente, D.S.; Fim Rosas, J.T.; Souza Santos, F.; Lima Dos Santos, F.F.; Nascimento, M.; Campana Nascimento, A.C. Site-Specific Nutrient Management Zones in Soybean Field Using Multivariate Analysis: An Approach Based on Variable Rate Fertilization. Commun. Soil Sci. Plant Anal. 2020, 51, 687–700. [Google Scholar] [CrossRef]
- Zhang, L.; Yang, L.; Ma, T.; Shen, F.; Cai, Y.; Zhou, C. A Self-Training Semi-Supervised Machine Learning Method for Predictive Mapping of Soil Classes with Limited Sample Data. Geoderma 2021, 384, 114809. [Google Scholar] [CrossRef]
- Tu, J.; Yang, G.; Qi, P.; Ding, Z.; Mei, G. Comparative Investigation of Parallel Spatial Interpolation Algorithms for Building Large-Scale Digital Elevation Models. Peerj Comput. Sci. 2020, 6, e263. [Google Scholar] [CrossRef]
- Dong, W.; Wu, T.; Luo, J.; Sun, Y.; Xia, L. Land Parcel-Based Digital Soil Mapping of Soil Nutrient Properties in an Alluvial-Diluvia Plain Agricultural Area in China. Geoderma 2019, 340, 234–248. [Google Scholar] [CrossRef]
- Girvan, M.S.; Bullimore, J.; Pretty, J.N.; Osborn, A.M.; Ball, A.S. Soil type is the primary determinant of the composition of the total and active bacterial communities in arable soils. Appl. Environ. Microbiol. 2003, 69, 1800–7809. [Google Scholar] [CrossRef]
- Lemaire, G.; Franzluebbers, A.; Carvalho, P.C.; Dedieu, B. Integrated crop-livestock system: Strategies to achieve synergy between agricultural production and environmental quality. Agric. Ecosyst. Environ. 2014, 190, 4–8. [Google Scholar] [CrossRef]
- Martinez-Selgado, M.M.; Gutierrez-Romero, V.; Jannsens, M.; Ortega-Blu, R. Biological soil quality indicators: A review. In Current Research, Technology and Education Topics in Applied Microbiology and Microbial Biotechnology, 1st ed.; Mendez-Vilas, A., Ed.; Microbiology Series N 2; Formatex Research Center: Badajoz, Spain, 2010; pp. 319–328. [Google Scholar]
- Nannipieri, P.; Ascher, J.; Ceccherini, M.T.; Landi, L.; Pietramellara, G.; Renella, G. Microbial diversity and soil function. Eur. J. Soil Sci. 2003, 54, 655–670. [Google Scholar] [CrossRef]
- Gajda, A. Mikrobiologiczne i Biochemiczne Wskaźniki Jakości Gleb Pod Pszenica w Zależności od Systemu Uprawy Roli; Monografie i Rozprawy Naukowe 46; Dział Upowszechniania i Wydawnictw; IUNG-PIB: Pulawy, Poland, 2015. [Google Scholar]
- Wagg, C.; Bender, S.F.; Widmerc, F.; van der Heijdena, M.G.A. Soil biodiversity and soil community composition determine ecosystem multifunctionality. Proc. Natl. Acad. Sci. USA 2014, 111, 5266–5270. [Google Scholar] [CrossRef]
- Johns, C. Living Soils: The Role of Microorganisms in Soil Health; Future Directions International Pty Ltd.: Dalkeith, WA, Australia, 2017; pp. 1–7. [Google Scholar]
- Karlen, D.L.; Andrew, S.S.; Wienhold, B.J.; Doran, J.W. Soil quality: Humankind’s foundation for survival. J. Soil Water Conserv. 2003, 58, 171–179. [Google Scholar]
- He, Z.L.; Yang, X.E.; Baligar, V.C.; Calvert, D.V. Microbiological and biochemical indexing systems for assessing quality of acid soils. Adv. Agron. 2003, 78, 89–138. [Google Scholar]
- Trasar-Cepeda, C.; Leirós, M.C.; Seoane, S.; Gil-Sotres, F. Limitations of soil enzymes as indicators of soil pollution. Soil Biol. Biochem. 2000, 32, 1867–1875. [Google Scholar] [CrossRef]
- Nielsen, M.N.; Winding, A. Microorganisms as Indicators of Soil Health; Technical Report No. 388; National Environmental Research Institute: Roskilde, Denmark, 2002. [Google Scholar]
- Anderson, T.H. Microbial eco-physiological indicators to assess soil quality. Agric. Ecosys. Environ. 2003, 98, 285–293. [Google Scholar] [CrossRef]
- Bloem, J.; Hopkins, D.; Benedetti, A. Microbiological Methods for Assessing Soil Quality; CABI Publishing: Cambridge, UK, 2006. [Google Scholar]
- Kennedy, P.; Smith, K.L. Soil microbial diversity and sustainability of agricultural soils. Plant Soil 1995, 170, 75–86. [Google Scholar] [CrossRef]
- Pankhurst, C.E.; Hawke, B.G.; MacDonald, H.J.; Kirkby, C.A.; Buckerfield, J.C.; Michelsen, P.; O’brien, K.A.; Gupta, V.V.S.R.; Doube, B.M. Evaluation of soil biological properties as potential bioindicators of soil health. Aust. J. Exp. Agric. 1995, 35, 1015–1028. [Google Scholar] [CrossRef]
- Sharma, S.K.; Ramesh, A.; Sharma, M.P.; Joshi, O.P.; Govaerts, B.; Steenwerth, K.L.; Karlen, D.L. Microbial Community Structure and Diversity as Indicators for Evaluating Soil Quality. In Biodiversity, Biofuels, Agroforestry and Conservation Agriculture. Sustainable Agriculture Reviews; Lichtfouse, E., Ed.; Springer: Dordrecht, The Netherlands, 2010; Volume 5. [Google Scholar] [CrossRef]
- Takahashi, Y.; Omura, S. Isolation of new actinomycete strains for the screening of new bioactive compounds. J. Gen. Appl. Microbiol. 2003, 49, 141–154. [Google Scholar] [CrossRef]
- Singh, S.; Nain, L. Microorganisms in the conversion of agricultural wastes to compost. Proc. Indian Natl. Sci. Acad. 2014, 80, 473–481. [Google Scholar] [CrossRef]
- Kumar, A.; Dubey, A. Rhizosphere microbiome: Engineering bacterial competitiveness for enhancing crop production. J. Adv. Res. 2020, 24, 337–352. [Google Scholar] [CrossRef]
- Mayer, M.; Prescott, C.E.; Abaker, W.E.; Augusto, L.; Cécillon, L.; Ferreira, G.W.; Vesterdal, L. Tamm Review: Influence of forest management activities on soil organic carbon stocks: A knowledge synthesis. For. Ecol. Manag. 2020, 466, 118127. [Google Scholar] [CrossRef]
- Cui, X.; Zhang, Y.; Gao, J.; Peng, F.; Gao, P. Long-term combined application of manure and chemical fertilizer sustained higher nutrient status and rhizospheric bacterial diversity in reddish paddy soil of Central South China. Sci. Rep. 2018, 8, 16554. [Google Scholar] [CrossRef] [PubMed]
- Altieri, M.A.; Nicholls, C.I.; Henao, A.; Lana, M.A. Agroecology and the design of climate change-resilient farming systems. Agron. Sustain. Dev. 2015, 35, 869–890. [Google Scholar] [CrossRef]
- Tripathi, S.; Srivastava, P.; Devi, R.S.; Bhadouria, R. Influence of synthetic fertilizers and pesticides on soil health and soil microbiology. In Agrochemicals Detection, Treatment and Remediation; Butterworth-Heinemann: Oxford, UK, 2020; pp. 25–54. [Google Scholar]
- Montes, F.; Meinen, R.; Dell, C.; Rotz, A.; Hristov, A.N.; Oh, J.; Dijkstra, J. Special Topics—Mitigation of methane and nitrous oxide emissions from animal operations: II. A review of manure management mitigation. J. Anim. Sci. 2013, 91, 5070–5094. [Google Scholar] [CrossRef] [PubMed]
- Jose, P.A.; Jha, B. New dimensions of research on Actinomycetes: Quest for next generation antibiotics. Front. Microbiol. 2016, 7, 1295. [Google Scholar] [CrossRef]
- Gomez-Escribano, J.P.; Alt, S.; Bibb, M.J. ext Generation Sequencing of Actinobacteria for the Discovery of Novel Natural Products. Mar. Drugs 2016, 14, 78. [Google Scholar] [CrossRef]
- Katz, L.; Baltz, R.H. Natural product discovery: Past, present, and future. J. Ind. Microbiol. Biotechnol. 2016, 43, 155–176. [Google Scholar] [CrossRef]
- Bhatti, A.A.; Haq, S.; Bhat, R.A. Actinomycetes benefaction role in soil and plant health. Microb. Pathog. 2017, 111, 458–467. [Google Scholar] [CrossRef]
- Loc, N.T.; Greinert, H. Wpływ osadu ściekowego na mikroflorę gleby oraz wzrost i skład chemiczny grochu siewnego (Pisum sativum L.). Folia Univ. Agric. Stetin. Agric. 2000, 83, 119–124. [Google Scholar]
- Acosta-Martinez, V.; Mikha, M.M.; Vigil, M.F. Microbial communities and enzyme activities in soils under alternative crop rotations compared to wheat-fallow for the Central Great Plains. Appl. Soil Ecol. 2007, 37, 41–52. [Google Scholar] [CrossRef]
- Crecchio, C.; Curci, M.; Pellegrino, A.; Ricciuti, P.; Tursi, N.; Ruggiero, P. Soil microbial dynamics and genetic diversity in soil under monoculture wheat grown in different long-term management systems. Soil Biol. Biochem. 2007, 39, 1391–1400. [Google Scholar] [CrossRef]
- Joniec, J.; Furczak, J. Liczebność wybranych grup drobnoustrojów w glebie bielicowej pod uprawą wierzby użyźnionej osadem ściekowym w drugim roku jego działania. Ann. Univ. Mariae Curie Skłodowska 2007, 62, 93–104. [Google Scholar]
- Birkhofer, K.; Bezemer, T.M.; Bloem, J.; Bonkowski, M.; Christensen, S.; Dubois, D.; Ekelund, F.; Fließbach, A.; Gunst, L.; Hedlund, K.; et al. Long-term organic farming fosters below and aboveground biota: Implications for soil quality, biological control and productivity. Soil Biol. Biochem. 2008, 40, 2297–2308. [Google Scholar] [CrossRef]
- Natywa, M.; Sawicka, A.; Wolna-Maruwka, A. Microbial and enzymatic activity in the soil under maize crop in relation to differentiated nitrogen fertilisation. Water Environ. Rural. Areas 2010, 2, 111–120. [Google Scholar]
- Weber, K.P.; Legge, R.L. Community-level physiological profiling. Methods Mol Biol. 2010, 599, 263–281. [Google Scholar]
- Sipilä, T.P.; Yrjälä, K.; Alakukku, L.; Palojärvi, A. Cross-site soil microbial communities under tillage regimes: Fungistasis and microbial biomarkers. Appl. Environ. Microbiol. 2012, 78, 8191–8201. [Google Scholar] [CrossRef]
- Martyniuk, S. Czy rolnictwo konwencjonalne (intensywne) szkodzi mikroorganizmom? Pol. J. Agron. 2014, 17, 25–29. [Google Scholar]
- Napora, A.; Grobelak, A. Wpływ osadów ściekowych na aktywność mikrobiologiczną i biochemiczną gleby. Inżynieria Ochr. Sr. 2014, 17, 619–630. [Google Scholar]
- Mahajan, G.R.; Manjunath, B.L.; Singh, N.P.; Ramesh, R.; Verma, R.R.; Latare, A.M.; D’Souza, R.; Barnes, N.; Kulkarni, R. Effect of organic and inorganic sources of nutrients on soil microbial activity and soil organic carbon build-up under rice in west coast of India. Arch. Agron. Soil Sci. 2016, 63, 414–426. [Google Scholar] [CrossRef]
- Maurer, C.; Müller, D.; Lanfranchi, M.; Weisskopf, P.; Oberholzer, H.; Walder, F. Mikrobiologische Parameter in der Kantonalen Bodenbeobachtung—Eine Synthese. Agrar. Schweiz 2020, 11, 147–153. [Google Scholar] [CrossRef]
- PN-ISO 10381-6:1998; Soil Quality—Sampling—Rules for the Collection, Handling and Storage of Soil Samples for the Study of Aerobic (Aerobic) Microbial Processes under Laboratory Conditions. International Organization for Standardization: Geneva, Switzerland, 2009.
- Duszkiewicz-Reinhard, W.; Grzybowski, R.; Sobczak, E. Teoria i Ćwiczenia z Mikrobiologii Ogólnej i Technicznej; Wydawnictwo SGGW: Warsaw, Poland, 2003; ISBN 83-7244-431-5. [Google Scholar]
- Ćwiczenie 7,8, Metody Ilościowe w Mikrobiologicznychbadaniach Żywności. Available online: https://uwm.edu.pl/wnz/sitefiles/file/mikrobiologia/%C4%87wiczenie_7,8-M%C5%BB-Mikrobiologia.pdf (accessed on 25 March 2024).
- Santos, I.C.; Hildenbrand, Z.; Schug, K.A. Applications of MALDI-TOF MS in environmental microbiology. R. Soc. Chem. 2016, 141, 2827–2837. [Google Scholar] [CrossRef]
- PN-R-04028:1997; Soil Chemical and Agricultural Analysis, Sampling and Determination of Nitrogen and Ammonium Ions in Mineral Soils. Polish Committee for Standardization: Warsaw, Poland, 1997.
- Faber, A. System rolnictwa precyzyjnego. I. Mapy plonów. Fragm. Agron. 1998, 15, 4–16. [Google Scholar]
- Kusz, A.; Marciniak, A.W. Niepewność w reprezentacji zjawisk przestrzennych. Inżynieria Rol. 2009, 5, 147–154. [Google Scholar]
- Walczykowa, M.; Zagórda, M.; Aboud, Z. Zmienność przestrzenna gleby w aspekcie jej wybranych właściwości fizycznych. Inżynieria Rol. 2005, 10, 375–384. [Google Scholar]
- Zawadzki, J. Wykorzystanie Metod Geostatystycznych w Badaniach Środowiska Przyrodniczego; Prace Naukowe Politechniki Warszawskiej. Inżynieria Środowiska; Oficyna Wydawnicza Politechniki Warszawskiej: Warsaw, Poland, 2005; Volume 49, p. 47. [Google Scholar]
- Małecka, I.; Blecharczyk, A.; Dobrzeniecki, T. Zmiany fizycznych i chemicznych właściwości gleby w wyniku stosowania uproszczeń w uprawie roli. Fragm. Agron. 2007, 24, 182–189. [Google Scholar]
- Blecharczyk, A.; Małecka, I.; Sierpowski, J. Wpływ wieloletniego oddziaływania systemów uprawy roli na fizyko-chemiczne właściwości gleby. Fragm. Agron. 2007, 24, 7–13. [Google Scholar]
- Lichter, K.; Govaerts, B.; Six, J.; Sayre, K.D.; Deckers, J.; Dendooven, L. Aggregation and C and N contents of soil organic matter fractions in a permanent raised-bed planting system in the Highlands of Central Mexico. Plant Soil 2008, 305, 237–252. [Google Scholar] [CrossRef]
- Yimer, F.; Ledin, S.; Abdelkadir, A. Changes in soil organic carbon and total nitrogen contents in three adjacent land use types in the Bale Mountains, south-eastern highlands of Ethiopia. For. Ecol. Manag. 2007, 242, 337–342. [Google Scholar] [CrossRef]
- Cenini, V.L.; Fornara, D.A.; McMullan, G.; Ternan, N.; Carolan, R.; Crawley, M.J.; Clément, J.-C.; Lavorel, S. Linkages between extracellular enzyme activities and the carbon and nitrogen content of grassland soils. Soil Biol. Biochem. 2016, 96, 198–206. [Google Scholar] [CrossRef]
- Małecka, I.; Swędrzyńska, D.; Blecharczyk, A.; Dytman-Hagedorn, M. Wpływ systemów uprawy roli pod groch na właściwości fizyczne, chemiczne i biologiczne gleby. Fragm. Agron. 2012, 29, 106–116. [Google Scholar]
- Kiełbasa, P.; Pikul, K.; Kurpaska, S.; Ostafin, M.; Zagórda, M. Wpływ Promieniowania Mikrofalowego na Stopień Eliminacji Mikroorganizmów w Wierzchniej Warstwie Gleby; Przegląd Elektrotechniczny; Wydawnictwo SIGMA-NOT: Warsaw, Poland, 2017; pp. 107–110. ISSN 0033-2097. [Google Scholar]
- Ingram, L.J.; Stahl, P.D.; Schuman, G.E.; Buyer, J.S.; Vance, G.F.; Ganjegunte, G.K.; Welker, J.M.; Derner, J.D. Grazing Impacts on Soil Carbon and Microbial Communities in a Mixed-Grass Ecosystem. Soil Sci. Soc. Am. J. 2008, 72, 939–948. [Google Scholar] [CrossRef]
- Liu, N.; Zhang, Y.; Chang, S.; Kan, H.; Lin, L. Impact of Grazing on Soil Carbon and Microbial Biomass in Typical Steppe and Desert Steppe of Inner Mongolia. PLoS ONE 2012, 7, 9. [Google Scholar] [CrossRef] [PubMed]
- Musiał, M.; Kryszak, J.; Grzebisz, W.; Wolna-Maruwka, A.; Łukowiak, R. Effect of Pasture Management System Change on In-Season Inorganic Nitrogen Pools and Heterotrophic Microbial Communities. Agronomy 2020, 10, 724. [Google Scholar] [CrossRef]
- Liu, X.; Cong, J.; Lu, H.; Xue, Y.; Wang, X.; Li, D.; Zhang, Y. Community structure and elevational distribution pattern of soil Actinobacteria in alpine grasslands. Acta Ecol. Sin. 2017, 37, 213–218. [Google Scholar] [CrossRef]
- Liu, J.J.; Sui, Y.Y.; Yu, Z.H.; Shi, Y.; Chu, H.Y.; Jin, J.; Liu, X.B.; Wang, G.H. High throughput sequencing analysis of biogeographical distribution of bacterial communities in the black soils of northeast China. Soil Biol. Biochem. 2014, 70, 113–122. [Google Scholar] [CrossRef]
- Sul, W.J.; Asuming-Brempong, S.; Wang, Q.; Tourlousse, D.M.; Penton, C.R.; Deng, Y.; Rodrigues, J.L.M.; Adiku, S.G.K.; Jones, J.W.; Zhou, J.Z.; et al. Tropical agricultural land management influences on soil microbial communities through its effect on soil organic carbon. Soil Biol. Biochem. 2013, 65, 33–38. [Google Scholar] [CrossRef]
- Ramirez, K.S.; Craine, J.M.; Fierer, N. Consistent effects of nitrogen amendments on soil microbial communities and processes across biomes. Glob. Chang. Biol. 2012, 18, 1918–1927. [Google Scholar] [CrossRef]

| Streptomyces albidoflavus [cfu/g Soil] | Streptomyces venezuelae [cfu/g Soil] | ||||||||
|---|---|---|---|---|---|---|---|---|---|
| Depth [m] | 0.05 | 0.15 | 0.25 | 0.35 | 0.05 | 0.15 | 0.25 | 0.35 | |
| Nitrate content [mg/100 g soil] | 0.05 | −0.52 | −0.52 | ||||||
| 0.15 | 0.19 | 0.19 | |||||||
| 0.25 | −0.59 | −0.57 | |||||||
| 0.35 | 0.26 | 0.22 | |||||||
Disclaimer/Publisher’s Note: The statements, opinions and data contained in all publications are solely those of the individual author(s) and contributor(s) and not of MDPI and/or the editor(s). MDPI and/or the editor(s) disclaim responsibility for any injury to people or property resulting from any ideas, methods, instructions or products referred to in the content. |
© 2025 by the authors. Licensee MDPI, Basel, Switzerland. This article is an open access article distributed under the terms and conditions of the Creative Commons Attribution (CC BY) license (https://creativecommons.org/licenses/by/4.0/).
Share and Cite
Miernik, A.; Korończok, J. Effect of Precision Nitrogen Fertilization of Grassland on Soil Microbial Structure. Appl. Sci. 2025, 15, 644. https://doi.org/10.3390/app15020644
Miernik A, Korończok J. Effect of Precision Nitrogen Fertilization of Grassland on Soil Microbial Structure. Applied Sciences. 2025; 15(2):644. https://doi.org/10.3390/app15020644
Chicago/Turabian StyleMiernik, Anna, and Jerzy Korończok. 2025. "Effect of Precision Nitrogen Fertilization of Grassland on Soil Microbial Structure" Applied Sciences 15, no. 2: 644. https://doi.org/10.3390/app15020644
APA StyleMiernik, A., & Korończok, J. (2025). Effect of Precision Nitrogen Fertilization of Grassland on Soil Microbial Structure. Applied Sciences, 15(2), 644. https://doi.org/10.3390/app15020644
